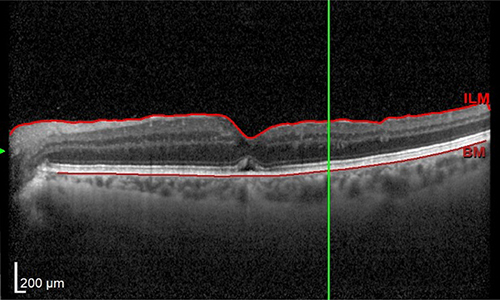
scaroni_immagine_foro_maculare_03

Il foro maculare è un piccolo “buco” che si forma al centro della macula, la zona più importante della retina, responsabile della visione centrale e dei dettagli.
È causato da una trazione sulla macula che provoca una microscopica rottura del tessuto.
Il foro maculare dà sintomi nel momento in cui si forma. Il paziente può notare:
• una piccola macchia nera centrale che impedisce di vedere bene ciò che si fissa;
• distorsione delle immagini (metamorfopsie), per cui linee dritte appaiono ondulate o storte, come i bordi delle porte o le fughe delle piastrelle.
Questi disturbi rendono difficile leggere, riconoscere i volti e vedere i dettagli.
Il foro maculare difficilmente si chiude spontaneamente. Senza trattamento tende ad aumentare di dimensioni, con un progressivo peggioramento della vista.
La terapia chirurgica offre invece alte probabilità di successo, soprattutto se il foro è di piccole dimensioni.
La diagnosi si basa su una visita oculistica completa e su un esame semplice, rapido e molto preciso: l’OCT.
L’OCT esegue una scansione della retina, simile a una TAC ma senza radiazioni, utilizzando solo raggi infrarossi. Questo permette di visualizzare il foro maculare e di misurarne con precisione le dimensioni.
Se il foro non si chiude spontaneamente, l’unico trattamento è l’intervento chirurgico di vitrectomia.
L’intervento, eseguito in anestesia locale, consiste nel rimuovere il vitreo (il gel che riempie l’occhio) e sostituirlo con un gas, pulire la retina da una membrana superficiale che mantiene aperto il foro. Il gas esercita una pressione sul foro e ne favorisce la chiusura.
Dopo l’intervento è fondamentale mantenere per alcuni giorni una posizione a faccia in giù (volto verso il basso), per permettere al gas di agire correttamente. La collaborazione del paziente è essenziale per il buon esito dell’intervento. Se la posizione non viene rispettata, la probabilità di chiusura del foro diminuisce notevolmente.
La guarigione dipende dalla chiusura del foro e dalle condizioni iniziali dell’occhio.
Se il foro si chiude, il recupero visivo è generalmente buono: la vista migliora in modo significativo, anche se non tornerà identica a quella di un occhio sano. Potrà persistere una lieve deformazione delle immagini o una visione non perfettamente nitida.
Se il foro dovesse rimanere aperto dopo il primo intervento, possono essere valutate procedure alternative.
La probabilità che un foro di dimensioni normali si chiuda con il primo intervento è di circa 90-95%.
Le informazioni riportate hanno scopo divulgativo e non sostituiscono una visita specialistica. Per una valutazione personalizzata e per conoscere benefici e possibili rischi dell’intervento, è necessario consultare il proprio oculista.